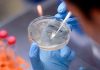

- Región
- Nuestros informes
- Proyectos sociales
- Nutriendo al Perú
- Juntos contra la violencia hacia las mujeres
- Ni golpes que duelan ni palabras que hieran
- Proyecto con varones para erradicar violencia de género
- Proyectos de vida
- Estado y sociedad contra la violencia de género
- Voces por la Igualdad
- Mujeres trabajando por la igualdad
- Emprendiendo por la igualdad
- Nuestras producciones
- RADIO EN VIVO
Desde su creación, en 1986, la radio ha tenido un enfoque educativo y cultural de creación de conciencia cívica y de rescate de la riqueza cultural de la población de Piura, desarrollando acciones de comunicación en espacios sociales, culturales, económicos y políticos.
Escríbenos a radiocutivalu@gmail.com
© INTELTA 2022. Todos los derechos reservados.
Potenciado por Távara Digital.
Potenciado por Távara Digital.

![“Soy enfermera y me infecté por segunda vez de Covid-19. Ahora toda mi familia está contagiada” [Testimonio]](https://archivo.cutivalu.pe/wp-content/uploads/2020/05/testimonio-lady-1-e1590693047591-100x70.jpg)

